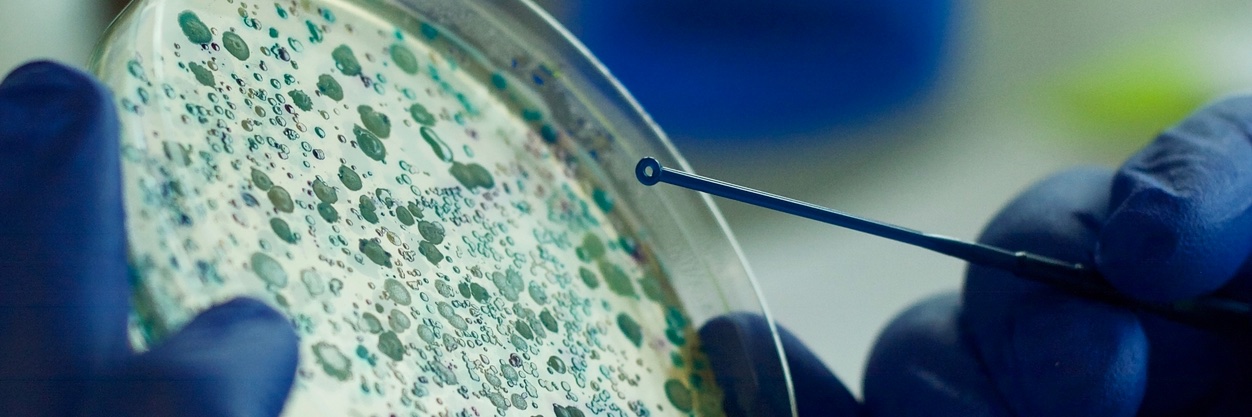
ModMedMicro banner

24 hours left to apply for these two posts to help us develop pipelines to process pathogens..!
Senior Bioinformatic Engineer
bit.ly/4ecl0hF
Senior Biostatistical Researcher
bit.ly/4kRfZxI
Grade 8 or 7, depending on experience
closing date: noon Tues 8 July
English